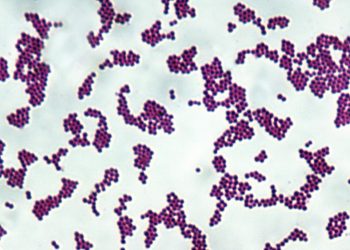
Do inimigo ao remédio: como bactérias estão sendo treinadas para curar o câncer

O presidente dos Estados Unidos, Donald Trump, disse que muito em breve vai reduzir as tarifas de importação que incidem sobre o café. Ele, no entanto, não detalhou quais países produtores serão beneficiados pela medida.
A declaração foi feita durante entrevista de Trump ao programa The Ingraham Angle, da Fox News, na terça-feira (11).
“Vamos reduzir algumas tarifas e vamos deixar entrar mais café. Tudo isso acontecerá muito rápido e com muita facilidade. É um processo cirúrgico bonito de se ver. Nossos custos de importação estão muito mais baixos”, declarou o presidente norte-americano após ser questionado sobre a alta dos preços nos EUA.
Nesta quarta-feira (12), a informação foi confirmada pelo secretário do Tesouro dos EUA, Scott Bessent, em outro programa da emissora, o Fox and Friends. Segundo Bessent, os norte-americanos verão “anúncios substanciais” nos próximos dias com o objetivo de reduzir os preços de produtos como café, bananas e outros itens não cultivados nos Estados Unidos.
Bessent também não entrou em detalhes sobre como essa redução de tarifas será conduzida. Disse apenas que os preços serão reduzidos “muito rapidamente” e que os norte-americanos começarão a se sentir melhor em relação à economia no primeiro semestre de 2026.Até 2024, os EUA figuravam entre os principais destinos do café produzido no Brasil e o principal importador de cafés especiais brasileiros, adquirindo aproximadamente 2 milhões de sacas do produto, a uma receita superior a US$ 550 milhões ao ano.
Segundo o Conselho dos Exportadores de Café (Cecafé), o café brasileiro representa mais de 30% do mercado norte-americano. O Brasil é o principal exportador de café para os Estados Unidos, destino de 16% das exportações brasileiras do produto.
A Agência Brasil contatou o Ministério do Desenvolvimento, Indústria, Comércio e Serviços (MDIC) e o Itamaraty, e está aberta à manifestações.
As duas pastas aguardam declaração oficial do governo norte-americano.